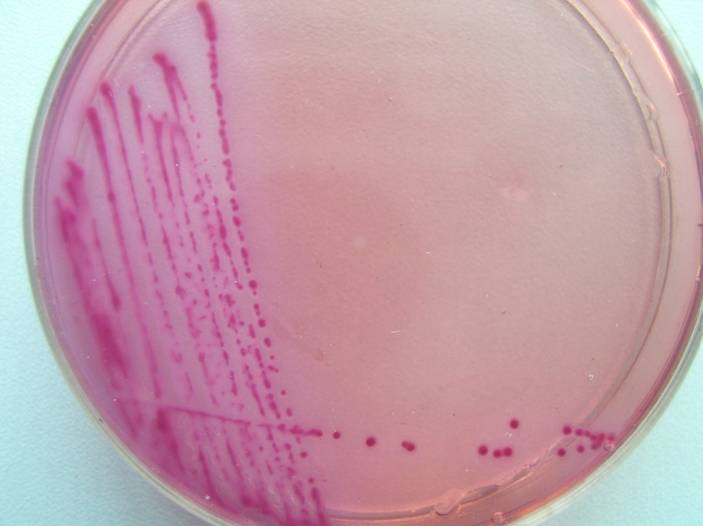

海博微信公众号
海博微信公众号
 海博天猫旗舰店
海博天猫旗舰店


 海博微信公众号
海博微信公众号
 海博天猫旗舰店
海博天猫旗舰店




VRBA琼脂:
配方(g/L):
蛋白胨 7.0
酵母粉 3.0
乳糖 10.0
3号胆盐 1.5
中性红 0.03
结晶紫 0.002
氯化钠 5.0
琼脂 15.0
pH 7.4±0.1 25℃
其中蛋白胨提供氮源;酵母粉提供生长促进因子和B族维生素;乳糖提供碳源,大肠菌群发酵乳糖,产生酸性物质;3号胆盐是一种抑菌剂,主要是抑制革兰氏阳性菌;结晶紫也是一种抑菌剂,主要是抑制革兰氏阳性菌和一部分革兰氏阴性菌;中性红是一种指示剂,在酸性条件显红色,碱性条件下显无色。氯化钠维持细菌生长时的渗透压。
琼脂是一种凝固剂。
LST

下一篇:气单胞菌与布鲁氏杆菌概述



